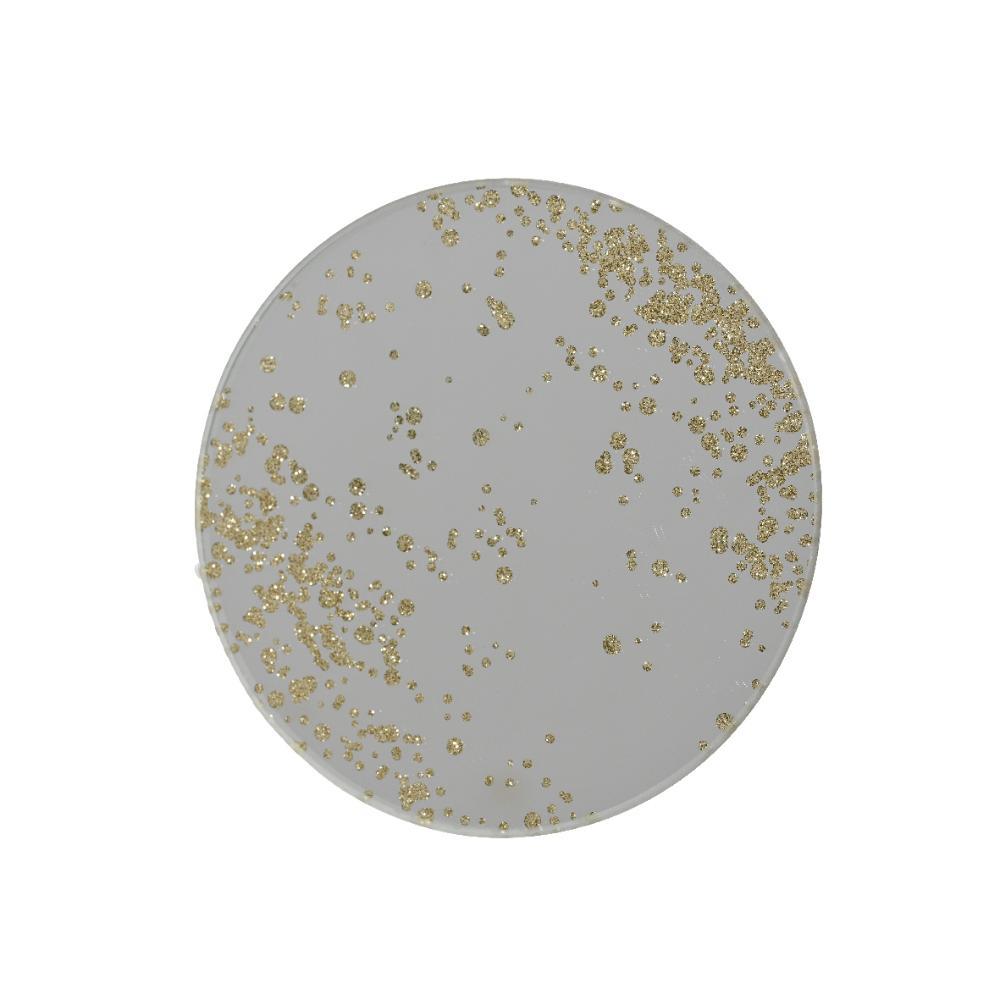

Couldn't load pickup availability
Kitchen Goods Glass Presentation Plate Silver Bring a touch of elegance to your holiday table setting with the Kitchen Goods Glass Presentation Plate in stunning silver. Ideal for festive gatherings, this round plate is crafted from fine glass and adds a sophisticated shine to any occasion. - colour: Silver - Material: Glass - Diameter: 10 cm - Height: 0.3 cm - Shape: Round - Indoor use Designed to impress, this presentation plate is perfect for showcasing your favorite holiday treats or decorative centerpieces. Its compact size makes it versatile for a variety of uses, from appetizer displays to charming dessert presentations. Simply place it on your dining table to elevate your Christmas decorations with a metallic flair, creating a festive atmosphere for you and your guests to enjoy. Lightweight and easy to handle, this plate is sure to become a cherished part of your seasonal essentials. Transform your home into a winter wonderland with this delightful addition to your holiday decor.
Free deliveries to all of Malta and Gozo for purchases of €50 and over or a charge of €10 for purchases under the €50 mark.
We will try and deliver within 3 - 4 days. Please also note that deliveries to Gozo might take up to 4 -5 days.
Clients choosing Store Pick Up need to first receive a call from our team who will be advising that order is ready for collection.
Our delivery team will only deliver at ground floor level. Please also note that any needed permits, crane and lifter service costs are to be taken care of and paid for by the client.
All our bulky products come flat packed. Should you need installation for the purchased product/s, kindly highlight to our customer care representative when contacted for delivery. An installation fee will be charged on delivery. Installation is only available on furniture and BBQ units.
No manuals or assembly files available.